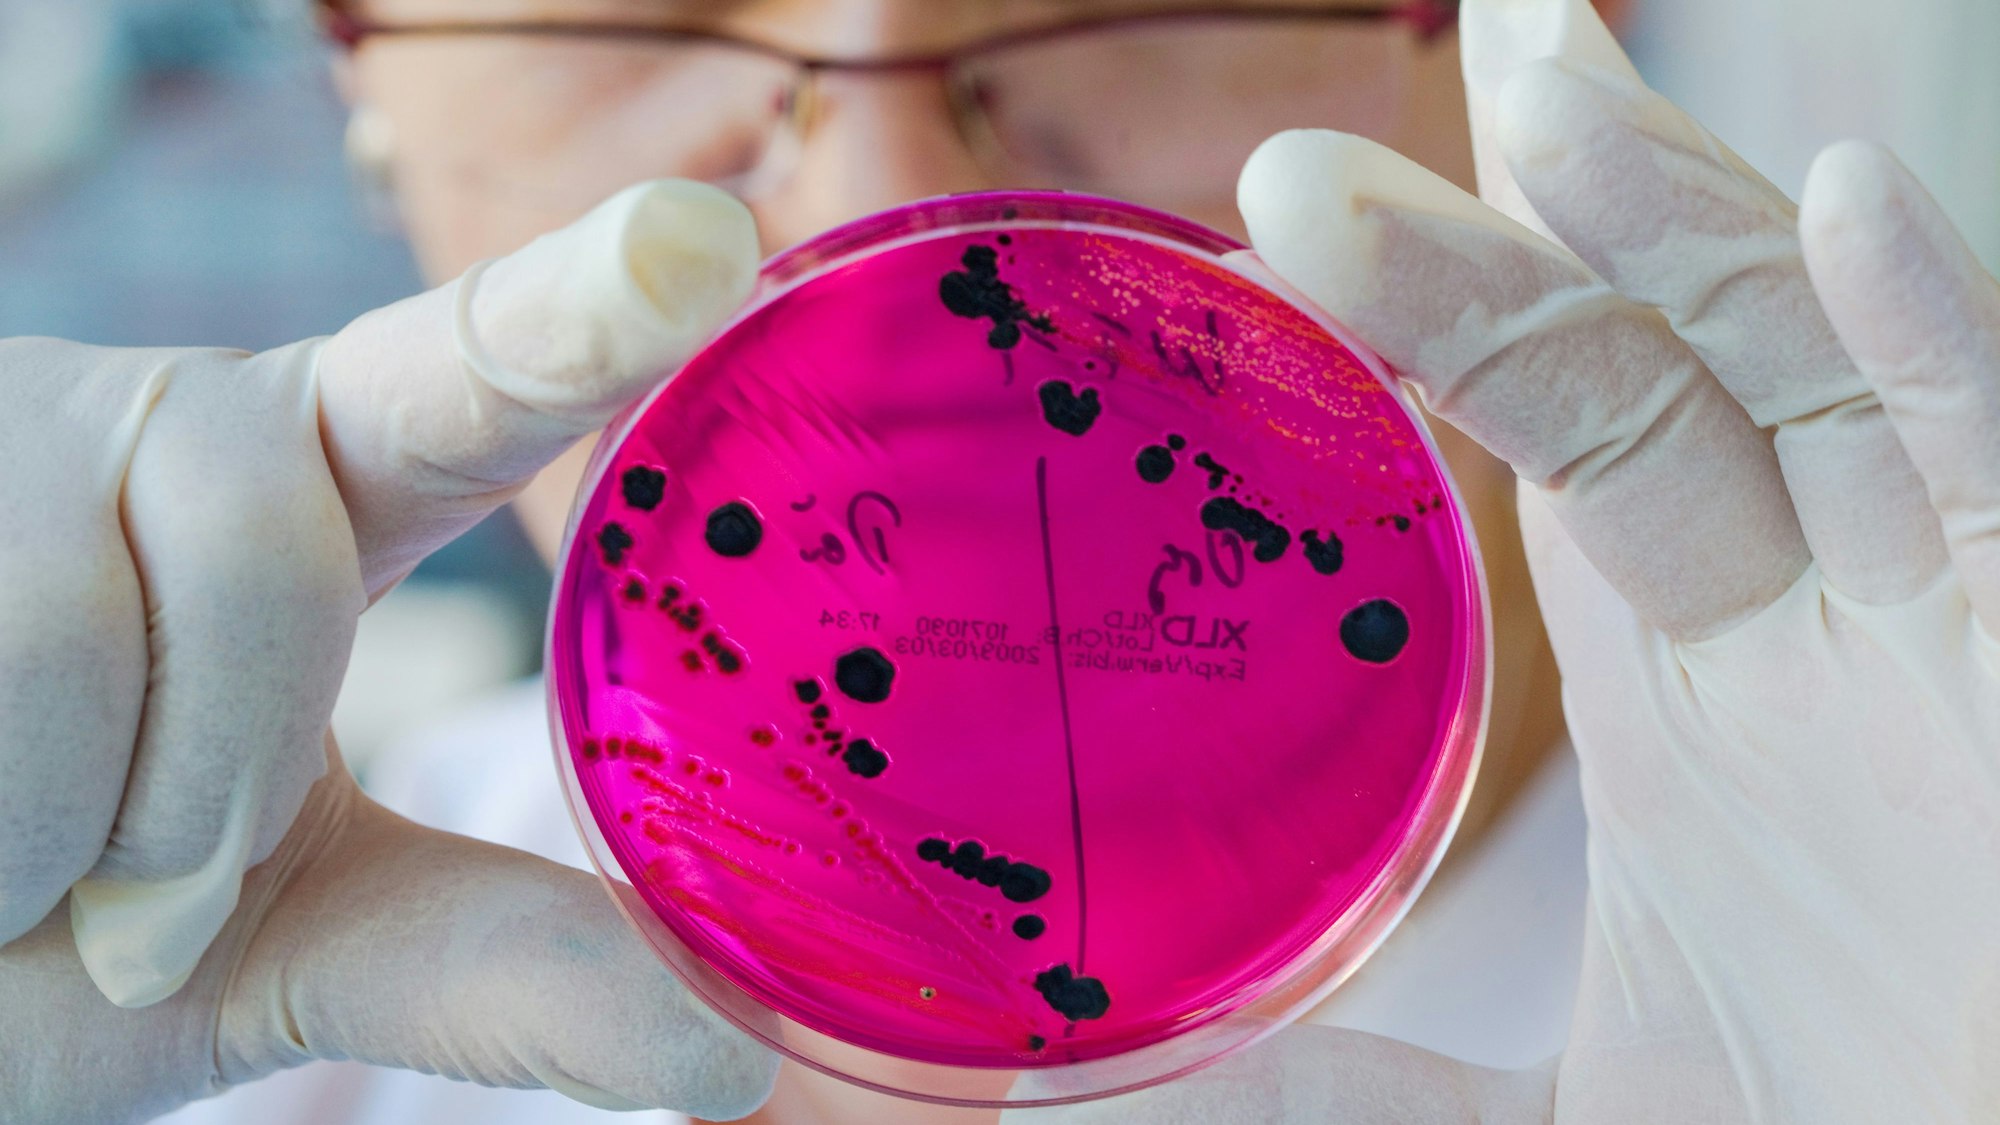

Erneut kommt es zu einem dringenden Rückruf eines Lebensmittels. Diesmal ist ein Pistazien-Produkt betroffen, welches Salmonella-Bakterien aufweist. Was bedeutet das und worauf sollte man achten?
Achtung, SalmonellenDringender Rückruf: Vorsicht vor diesem Pistazien-Produkt
Copyright: picture-alliance/ dpa
Regelmäßig werden Lebensmittel zurückgerufen. Oft sind Salmonellen der Grund dafür. Auf dem Foto, aufgenommen am 12. Januar 2009 in Frankfurt, sieht man Salmonellen auf einem Nährboden.
17.11.2021, 12:15
Köln. Wer Pistazien mag und gerne Produkte mit Pistazien kauft, der sollte jetzt unbedingt in seinen Kühlschrank schauen. Denn es wurde ein Rückruf veröffentlicht, den Verbraucher sehr ernst nehmen sollten.
Bei dem betroffenen Produkt handelt es sich um die „AL-BURJ Tahini (Sesam) Pistazien-Soße“ von der Al Safir Handels GmbH. Der Grund für den Rückruf: Salmonellen. In einigen Labor-Untersuchungen wurde festgestellt, dass das Produkt die gefährlichen Salmonella-Bakterien aufweist.
„AL-BURJ Tahini (Sesam) Pistazien-Soße“ nicht verzehren
- Produkt: AL-BURJ Tahini (Sesam) Pistazien-Soße
- Verpackungseinheit: 800g Becher
- Mindesthaltbarkeitsdatum: 07.2022
- Hersteller (Inverkehrbringer): Al Safir Handels GmbH
Wer die „AL-BURJ Tahini (Sesam) Pistazien-Soße“ gekauft hat, die mit den oben angegebenen Daten übereinstimmt, sollte es laut „produktwarnung.eu“ zurück in die jeweilige Verkaufsstelle zu bringen. Vor dem verzehr wird gewarnt.
Salmonellen lösen Magen-Darm-Infektionen aus
Wer das Produkt trotzdem isst oder bereits gegessen hat, dem droht vermutlich eine schwere Magen-Darm-Infektion, denn die löst der Verzehr von Lebensmitteln aus, die Salmonella-Bakterien enthalten. Das bedeutet: Durchfall, Übelkeit, Erbrechen und teilweise Fieber, Kopf- und Bauchschmerzen. Die Symptome treten nach 12 bis 36 Stunden auf und dauern aber nur wenige Stunden an.
Diese Tipps helfen, eine Salmonellenvergiftung vorzubeugen
Doch in welchen Produkten können diese Bakterien überhaupt entstehen? Meistens fallen Lebensmittel aus Nutztiererzeugnissen der Verseuchung durch Salmonellen zum Opfer, also beispielsweise nicht ausreichend hoch erhitztes Rinder- oder Hähnchenfleisch, Eier oder eihaltige Produkte.
Salmonellen sind sehr hartnäckig und können sich leicht und schnell vermehren. Es ist daher wichtig, dass sich Verbraucher gut vor Salmonellen und einer Infektion zu schützen. Diese Tipps können dabei helfen:
- Für Salmonellen anfällige Lebensmittel immer im Kühlschrank lagern
- Schneidebretter, Messer, Spülschwämme und andere Küchenutensilien gründlich und regelmäßig reinigen
- Regelmäßig Händewaschen (Nach jedem Toilettengang, nach Kontakt mit tierischen Nutzerzeugnissen etc.)
- Oberflächen (heiß) reinigen und das Abtauwasser von gefrorenem Geflügel oder Wild separat auffangen und entsorgen
- Nicht auf über 70 Grad Celsius erhitzbare Lebensmittel getrennt von rohen Lebensmitteln lagern
In welchen Bundesländern wird die „AL-BURJ Tahini (Sesam) Pistazien-Soße“ verkauft?
In welchen Bundesländern gibt es die „AL-BURJ Tahini (Sesam) Pistazien-Soße“ von der Al Safir Handels GmbH zu kaufen? Laut „Lebensmittelwarnung.de“ sind folgende Bundesländer betroffen:
- Nordrhein-Westfalen
- Thüringen
- Rheinland-Pfalz
Wer das Produkt verzehrt hat und Symptome einer Salmonellenvergiftung aufweist, sollte unverzüglich einen Arzt aufsuchen. Gerade für ältere Menschen, Kinder und Immunschwache kann der Verzehr gefährlicher werden. (sai)